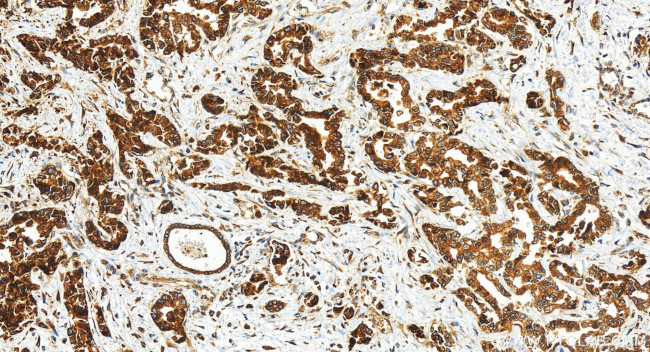
LASS2 Antibody in Immunohistochemistry (Paraffin) (IHC (P))

Search
Proteintech
LASS2 Polyclonal Antibody
{{$productOrderCtrl.translations['antibody.pdp.commerceCard.promotion.promotions']}}
{{$productOrderCtrl.translations['antibody.pdp.commerceCard.promotion.viewpromo']}}
{{$productOrderCtrl.translations['antibody.pdp.commerceCard.promotion.promocode']}}: {{promo.promoCode}} {{promo.promoTitle}} {{promo.promoDescription}}. {{$productOrderCtrl.translations['antibody.pdp.commerceCard.promotion.learnmore']}}
产品信息
30183-1-AP
种属反应
宿主/亚型
分类
类型
抗原
偶联物
形式
浓度
规格
纯化类型
保存液
内含物
保存条件
运输条件
产品详细信息
Immunogen sequence: TPLAALLNIK EKTRLRAPPN ATLEHFYLTS GKQPKQVEVE LLSRQSGLSG RQVERWFRRR RNQDRPSLLK KFREA
靶标信息
LASS2 is a protein that has sequence similarity to yeast longevity assurance gene 1. Mutation or overexpression of the related gene in yeast has been shown to alter yeast lifespan. The human protein may play a role in the regulation of cell growth. This gene encodes a protein that has sequence similarity to yeast longevity assurance gene 1. Mutation or overexpression of the related gene in yeast has been shown to alter yeast lifespan. The human protein may play a role in the regulation of cell growth. Alternatively spliced transcript variants encoding the same protein have been described.
仅用于科研。不用于诊断过程。未经明确授权不得转售。
篇参考文献 (0)
生物信息学
蛋白别名: Ceramide synthase 2; CerS2; FLJ10243; LAG1 homolog, ceramide synthase 2; LAG1 longevity assurance 2; LAG1 longevity assurance homolog 2; longevity assurance (LAG1, S. cerevisiae) homolog 2; longevity assurance homolog 2; MGC987; SP260; Sphingosine N-acyltransferase CERS2; TRAM homolog 3; Translocating chain-associating membrane protein homolog 3; Tumor metastasis-suppressor gene 1 protein; unnamed protein product; Very-long-chain ceramide synthase CERS2
基因别名: 0610013I17Rik; AI225939; CERS2; L3; LASS2; SP260; TMSG1; TRH3
UniProt ID: (Human) Q96G23, (Mouse) Q924Z4
Entrez Gene ID: (Human) 29956, (Mouse) 76893, (Rat) 310667